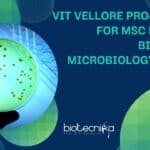
VIT Vellore Project Job

Home Search
biology - search results
If you're not happy with the results, please do another search
MACS-ARI Pune MSc & PhD Microbiology/ Biotech/ Biochem Research Job, Apply Online
MACS-ARI Pune MSc & PhD Microbiology/ Biotech/ Biochem Research Job, Apply Online
MACS-ARI Pune MSc & PhD Microbiology/ Biotech/ Biochem Research Job, Apply Online. MSc...
IMTECH Bioinformatics, Mol Bio & Microbiology Project Job, Apply Online
IMTECH Bioinformatics, Mol Bio & Microbiology Project Job, Apply Online
IMTECH Bioinformatics, Mol Bio & Microbiology Project Job, Apply Online. CSIR – IMTECH is Hiring...
GSK BSc, MSc Life Sciences, Biotech, Biochem & Biology Job Opening, Apply Online
GSK Hiring MSc Biochemistry, Biotech, Biology & Life Science- Apply Online
GlaxoSmithKline (or GSK) is a global biopharma company with a special purpose – to...
VIT Vellore Project Job For MSc Biotech, Biochem & Microbiology – Apply Online
VIT Vellore Project Job For MSc Biotech, Biochem & Microbiology - Apply Online
VIT Vellore Project Job For MSc Biotech, Biochem & Microbiology - Apply...
IISER Kolkata Project Associate Biotech, Zoology & Microbiology Job
IISER Kolkata MSc Zoology, Biotech & Microbiology Job
IISER Kolkata MSc Zoology, Biotech & Microbiology Job. MSc jobs. MSc Microbiology, Zoology & Biotechnology Project Associate...
PEGGS INDIA QC Microbiologist For BSc Biology & Food Science, Apply Online
PEGGS INDIA QC Microbiologist For BSc Biology & Food Science, Apply Online
PEGGS INDIA QC Microbiologist For BSc Biology & Food Science, Apply Online. PEGGS...
BNHS Grad & Postgrad Biology & Life Sciences Apply For Project Associate Job
BNHS Project Associate Vacancy For BSc, MSc Biology & Life Sciences - Applications Invited
BNHS Project Associate Vacancy For BSc, MSc Biology & Life Sciences...
BNHS Grad & Postgrad Life Sciences, Zoology & Biology Apply For Project Associate Job
BNHS Project Associate Job For BSc, MSc Zoology, Biology & Life Sciences - Applications Invited
BNHS Project Associate Job For BSc, MSc Zoology, Biology &...
Amity Institute of Biotechnology JRF Job For MSc, MTech Microbiology & Immunology Candidates
Amity Institute of Biotechnology JRF Job For MSc, MTech Microbiology & Immunology Candidates
Amity Institute of Biotechnology JRF Job For MSc, MTech Microbiology & Immunology...
MSc, MTech Biotech, Cell Biology & Life Sciences Research Associate Job a Syngene
Syngene Research Associate Job For MSc, MTech Life Sciences, Biotech, Cell Biology
Syngene Research Associate Job For MSc, MTech Life Sciences, Biotech, Cell Biology. MSc,...
BSc Food Science, Microbiology R&D Specification Writer Job at Pepsi, Apply Online
Pepsi India R&D Writer Job For BSc Food Science, Microbiology Candidates, Apply Online
Pepsi India R&D Writer Job For BSc Food Science, Microbiology Candidates, Apply...
Jubilant Biosys Hiring Research Associate / Senior Research Associate in Discovery Biology Dept.
Jubilant Biosys Hiring Research Associate / Senior Research Associate in Discovery Biology Dept.
Jubilant Biosys Hiring Research Associate / Senior Research Associate in Discovery Biology...
NCCS Pune Multiple Research Project Opening For Mol Bio, Biochem, Cell Biology Candidates
NCCS Pune Biochem, Mol Bio & Cell Biology Research Jobs - Apply Online
NCCS Pune Biochem, Mol Bio & Cell Biology Research Jobs - Applications...
PGIMER Bioinformatics & Cell Biology JRF Job – Applications Invited
PGIMER Bioinformatics & Cell Biology JRF Job - Applications Invited
PGIMER Bioinformatics & Cell Biology JRF Job - Applications Invited. MSc Bioinformatics and Cell Biology...
Biotecnika Times Newsletter 28.06.2023 UPSC Biology Jobs, THSTI-Manipal PhD Admissions, National Workshop, Internships +...
Biotecnika Times Newsletter 28.06.2023 UPSC Biology Jobs, THSTI-Manipal PhD Admissions, National Workshop, Internships + Much More
UPSC Biology Scientific Officer - MSc & BTech Apply...